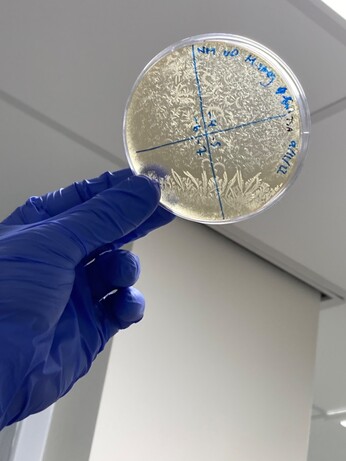

Margherita Pevere · @margherita_pevere
31 followers · 51 posts · Server mastodon.worldI will join a Panel Discussion titled Tackling Challenges in Implementation of the field of Biodesignon the 3rd of February at Darwin Conference.
session among the many others happening from 2nd-5th February, in hybrid mode .
panel discussions, hands-on workshops, tours, paper presentations, Startup Summit, Biohackathon and more: www.thedarwin.in
You can sign up for the free conference here: thedarwin.in/attend-conference
#artisticresearch #BioArt #diybio #conference
Margherita Pevere · @margherita_pevere
29 followers · 44 posts · Server mastodon.worldMembranes Out Of Order "sets out to explore membranes both as material and metaphor, as well as the uncertainty, potential failures, surprises, and disobediences that emerge when working with living materials."
Lyndsey Walsh reviews the show for Clot Magazine
#artisticResearch #death #posthumanism #ArtTalks #Bioart #QueerEcologies #Vulnerability #mastoart
#artisticresearch #death #posthumanism #arttalks #BioArt #queerecologies #vulnerability #mastoart
Margherita Pevere · @margherita_pevere
29 followers · 44 posts · Server mastodon.worldNow you can listen to the brilliant conversation with Daniela Silvestrin at Membranes Out of Order on #SoundCloud
https://soundcloud.app.goo.gl/sVQJJ
#artisticResearch #death #posthumanism #ArtTalks #Bioart #QueerEcologies #Vulnerability #MastoArt
#soundcloud #artisticresearch #death #posthumanism #arttalks #BioArt #queerecologies #vulnerability #mastoart
Margherita Pevere · @margherita_pevere
29 followers · 44 posts · Server mastodon.worldMembranes Out Of Order is an exhibition by and with Theresa Schubert, Karolina Żyniewicz and yours truly.
The show responds to ethical and cultural challenges posed by the interplay of biotechnology and ecology.
On view until January 8 at Kunstquartier Bethanien, Berlin
#art #bioart #artisticResearch #QueerEcologies #Death #MediaArt #PerformanceArt #MachineLearning #accessibility #EnvArt #ArtScience #EnvHum
#KarolinaŻyniewicz #TheresaSchubert
#performanceart #art #BioArt #artisticresearch #queerecologies #death #mediaart #machinelearning #accessibility #envart #artscience #envhum #karolinazyniewicz #theresaschubert
Margherita Pevere · @margherita_pevere
1 followers · 2 posts · Server mastodon.worldhttps://m-ooo.info
With artists Theresa Schubert and Karolina Zyniewicz I co-curated the exhibition "Membranes Out Of Order", open until January 8th 2023 ar Kunstquartier Bethanien Berlin.
#art #bioart #artisticResearch #QueerEcologies #Death #MediaArt #VisualArt #MachineLearning
#art #BioArt #artisticresearch #queerecologies #death #mediaart #visualart #machinelearning
Margherita Pevere · @margherita_pevere
29 followers · 44 posts · Server mastodon.worldhttps://m-ooo.info
With artists Theresa Schubert & Karolina Zyniewicz I co-curated the exhibition "Membranes Out Of Order", open until Jan 8 2023, Kunstquartier Bethanien Berlin.
"Bioart, video, sculpture, photography and drawing: Membranes Out Of Order brings the audience though vulnerability, monumentality and microscopic world(s)".
W/ accessibility for visually impaired audiences
#art #bioart #artisticResearch #QueerEcologies #Death #MediaArt #MachineLearning #accessibility #EnvArt
#art #BioArt #artisticresearch #queerecologies #death #mediaart #machinelearning #accessibility #envart
Margherita Pevere · @margherita_pevere
29 followers · 44 posts · Server mastodon.worldHello world. I am a lazy social media user but still hope to change my mind.
My art looks at things that are very small or very big, but always leaky.
I make art, give talks, write a lot.
#bioart #ArtisticResearch #EnvHum #QueerEcology #QueerDeath #PerformanceArt #Art #QueerStudies #FeministStudies #biohacking #artscience
#introduction #BioArt #artisticresearch #envhum #queerecology #queerdeath #performanceart #art #queerstudies #FeministStudies #biohacking #artscience
Julien Baylac · @JulienBaylac
7 followers · 45 posts · Server mastodon.worldOrlan (Mireille Porte) | #France
site - http://orlan.eu
#art #performance #photo #painting #bioart
#france #art #performance #photo #painting #BioArt
Heidi Hehnly-Chang · @HehnlyChang
2 followers · 1 posts · Server mstdn.scienceOne of my favorite things about Syracuse University's #BioArt Mixer is our Posters, and now you can see some of our favorites on display in our Pop-Gallery on the 2nd floor of the Life Science Complex. Come check them out if you are in the area!
Nick Martin · @NickMartin
8 followers · 1 posts · Server mstdn.scienceMy bacterial CFU plates weren’t taken out of the incubator over the weekend but it made a cool crystal formation #BioArt
Tim Dobbs · @timdobbs
53 followers · 8 posts · Server genomic.social#introduction (2)
I also built https://www.bioartbot.org, a #ScienceCommunication tool that lets anyone make #art with biology, i.e. #BioArt. The project is #OpenSource and distributed - if you've got a knack for #robots, #biology, or are just interested, shoot me a message. Together we can make all of this cool #science available to more people!
#introduction #sciencecommunication #art #BioArt #opensource #robots #biology #science